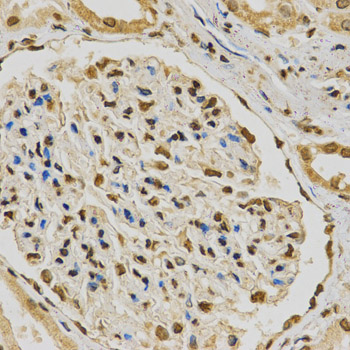
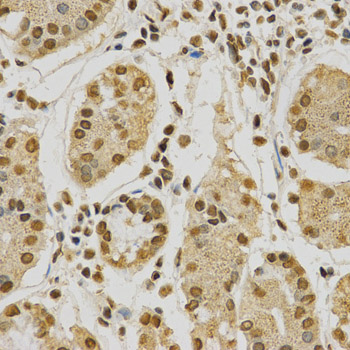

For quotations, please use our online quotation form, and you may also contact us by
service@kendallscientific.com
+1-888.733.6849 (Toll-free)
+1-617.299.7367 (Int’l))
+1-888.733.6849
Our customer service representatives are available 24 hours, Monday through Friday to assist you.| Reactivity | Human Mouse Rat |
| Tested applications | WB IHC IF |
| Recommended Dilution | WB 1:500 - 1:2000 IHC 1:50 - 1:200 IF 1:50 - 1:200 |
| Calculated MW | 37kDa |
| Observed MW | Refer to Figures |
| Immunogen | Recombinant protein of human HNRNPA2B1 |
| Storage Buffer | Store at -20℃. Avoid freeze / thaw cycles. Buffer: PBS with 0.02% sodium azide, 50% glycerol, pH7.3. |
| Concentration | j |
| Synonym | HNRNPA2B1;DKFZp779B0244;FLJ22720;HNRNPA2;HNRNPB1;HNRPA2;HNRPA2B1;HNRPB1;RNPA2;SNRPB1 ; |

Western blot analysis of extracts of various cell lines, using HNRNPA2B1 antibody.

Immunohistochemistry of paraffin-embedded human colon using HNRNPA2B1 antibody at dilution of 1:200 (x400 lens).
Immunohistochemistry of paraffin-embedded human kidney using HNRNPA2B1 antibody at dilution of 1:200 (x400 lens).
Immunohistochemistry of paraffin-embedded human stomach using HNRNPA2B1 antibody at dilution of 1:200 (x400 lens).

Immunohistochemistry of paraffin-embedded Mouse brain using HNRNPA2B1 antibody at dilution of 1:100 (x400 lens).

Immunohistochemistry of paraffin-embedded Mouse kidney using HNRNPA2B1 antibody at dilution of 1:100 (x400 lens).

Immunohistochemistry of paraffin-embedded Rat brain using HNRNPA2B1 antibody at dilution of 1:100 (x400 lens).

Immunohistochemistry of paraffin-embedded Rat kidney using HNRNPA2B1 antibody at dilution of 1:100 (x400 lens).

Immunohistochemistry of paraffin-embedded Rat liver using HNRNPA2B1 antibody at dilution of 1:100 (x400 lens).

Immunofluorescence analysis of HeLa cell using HNRNPA2B1 antibody. Blue: DAPI for nuclear staining.

Immunofluorescence analysis of A549 cell using HNRNPA2B1 antibody. Blue: DAPI for nuclear staining.
Heterogeneous nuclear ribonucleoprotein A2/B1 (hnRNP A2/B1) is a member of the hnRNP A/B family of related RNA binding proteins that bind pre-mRNA and are involved in the processing, metabolism and transport of nuclear pre-mRNA transcripts (1). Alternative splicing produces transcripts that encode two homologous hnRNP proteins, hnRNPA2 and hnRNPB1, from a single gene sequence (2). Studies demonstrate hnRNP A2/B1 splicing repression across multiple targets (3,4) and that both proteins can bind and protect telomere repeat sequences from DNase digestion (5,6). Altered expression of hnRNP B1 is seen in several forms of cancer, including squamous cell carcinoma, adenocarcinoma, and various forms of lung cancer (7). Over expression of hnRNP B1 may be associated with inhibition of DNA-PK activity and impaired DNA repair during early stages of cancer development (8). Autoantigens to hnRNP A2/B1 (termed RA33) are associated with rheumatoid arthritis, systemic lupus erythromatosus and mixed connective tissue disease (9-11).
N/A